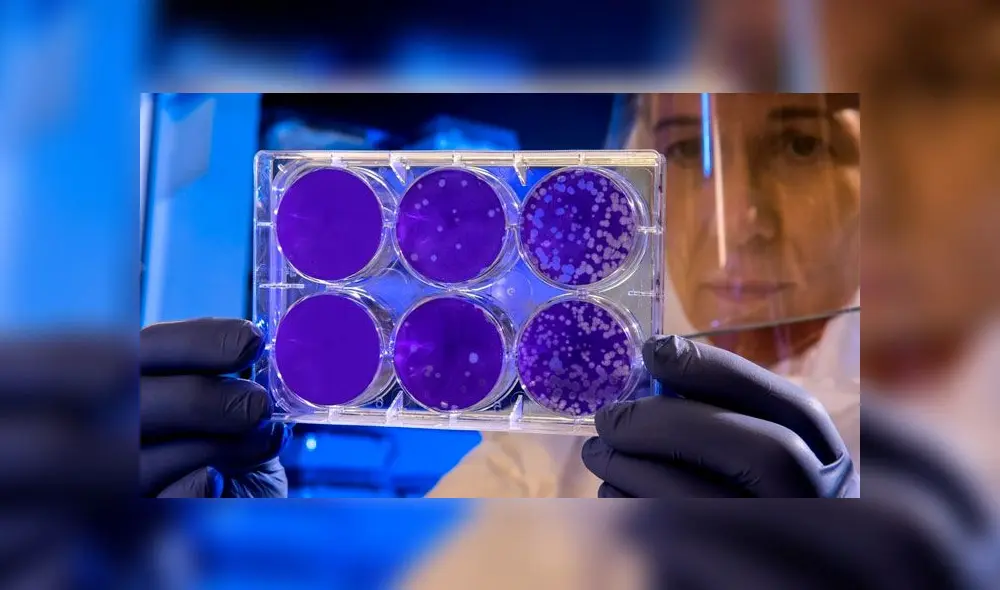
Científicos descubren el origen de la metástasis y están más cerca de la cura contra el cáncer

Científicos descubren el origen de la metástasis y están más cerca de la cura contra el cáncer
Un equipo estadounidense y español parece haber dado los primeros pasos por descifrar el origen del metástasis, que es el responsable del 90% de las muertes por cáncer.
- ¿Cuál es el país de América Latina que, después de Venezuela, tiene la mayor reserva de petróleo de la región?
- Este país de América Latina desafía al Canal de Panamá con un corredor que conecta 2 océanos y 3 continentes: estaría listo en 2026
Un equipo de científicos de Estados Unidos parece estar cada vez más cerca de la cura contra el cáncer. Recientemente, unos investigadores del Instituto Sloan Kettering de Nueva York dieron a conocer su última investigación sobre el origen de la metástasis.
Según el hallazgo liderado por el oncólogo español Joan Massegué, la metástasis del cáncer no se inician por mutaciones genéticas que habilitan a las células del tumor primario para migrar a otros órganos, tal y como se había creído hasta ahora.
TE RECOMENDAMOS
UN MU3RTO EN LA VÍA EXPRESA SUR DE LÓPEZ ALIAGA Y JERÍ EN LA MIRA|FUERTE Y CLARO CON MANUELA CAMACHO
La investigación, que fue publicada en la revista Nature Cancer, es un gran avance para el cáncer teniendo en cuenta que la metástasis - que es la propagación del cáncer a otras regiones del cuerpo - es responsable del 90 % de las muertes por esta enfermedad.
De esta manera, concluyeron que las células que inician las metástasis utilizan de manera maliciosa un mecanismo que, en los tejidos sanos, es beneficioso. Se trata de un mecanismo que permite regenerar los tejidos cuando sufren una rotura. Para ello, las células segregan una molécula llamada L1CAM, que permite la adhesión entre células y permite sellar las heridas.
“Ahora entendemos la metástasis como la regeneración del tejido equivocado -el tumor- en el lugar equivocado, los órganos vitales distantes”, dice Joan Massagué , director del Instituto Sloan Kettering, quien además lleva 30 años investigando.
Aunque la metástasis es mortal, no es algo que las células cancerígenas puedan realizar fácilmente. Para propagarse, las células cancerosas deben separarse con éxito de sus vecinas, atravesar las capas de tejido que las separan de la circulación, nadar o arrastrarse a una nueva ubicación en el cuerpo a través de la sangre o el líquido linfático, salir de estos vasos, luego echar raíces y comenzar a crecer en el nueva ubicación.

metástasis

















